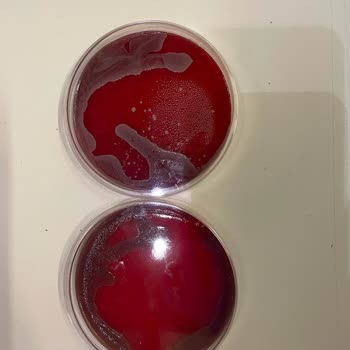
Tıp Kim San Ve Besimik Kontamine Ağar Gönderme Konusunda Çok Uzmanlar
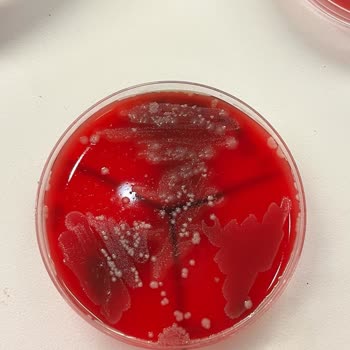
Tıp Kim San Ve Besimik Kontamine Ağar Gönderme Konusunda Çok Uzmanlar

Tıp Kim San Yanıltıcı Bilgi İle Müşteri Mağduriyeti

Karşıdan Çekmeköy, 60 km uzaklıktan ameliyat için bir ürün sordum, önce var dediler. Sonra geldiğimde depoya sorduk, yok dediler. Böyle bir yöntem de varmış. Telefon konuşmaları kayıtlı, savcılığa şikayet edeceğim.